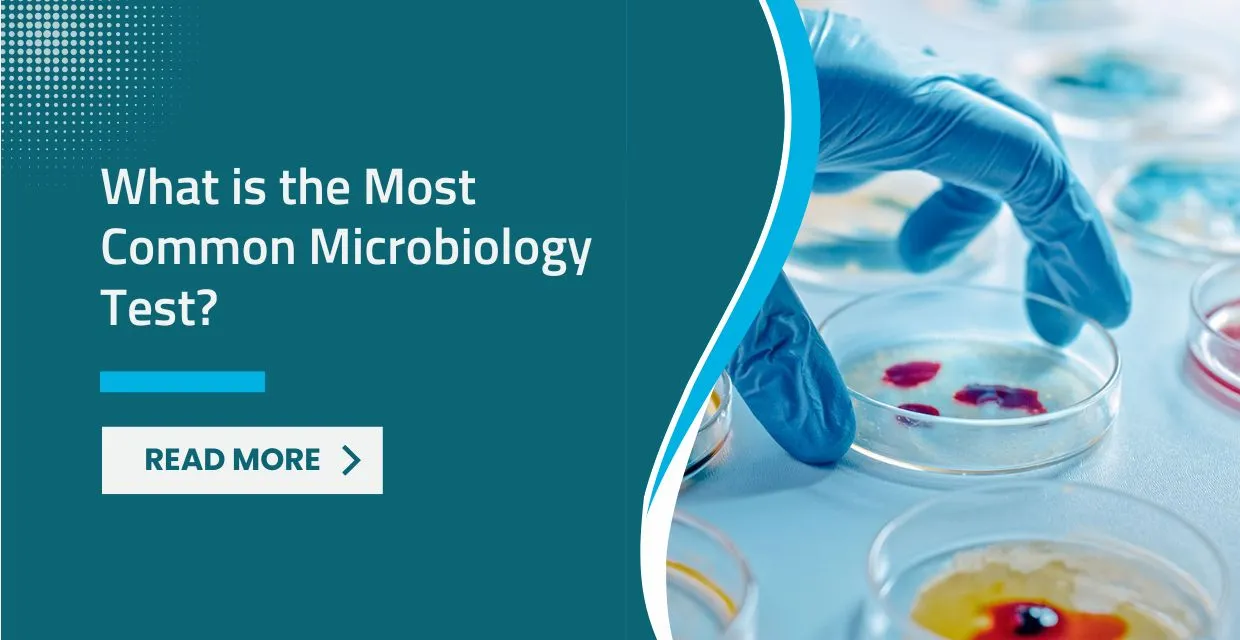
Clinical Microbiology Laboratory

What Is the Most Common Microbiology Test? Identifying the Invisible
Behind the scenes of every major hospital, away from the bustling ER and the sterile operating theaters, is a world of microscopes, petri dishes, and incubator machines. This is the **Microbiology Laboratory**. Here, scientists perform the detective work that allows doctors to know exactly what is making a patient sick. But of the hundreds of types of bacteria, viruses, and fungi we study, there is one test that stands out as the absolute most frequent.
At LifeCare Hospitals Kenya, our state-of-the-art microbiology labs process thousands of samples monthly. Understanding these tests helps patients appreciate why "instant" results aren't always possible and how we ensure you receive the right medicine for your specific infection. in this guide, we reveal the most common test in microbiology and explain the fascinating science behind it.
The Winner: The "Urine Culture and Sensitivity" (UC&S) Test1. Why is Urine Culture the Most Common?
Urinary Tract Infections (UTIs) are one of the most frequent reasons people seek medical care worldwide. They affect everyone from infants to the elderly, but are particularly common in women. While a "quick" dipstick test in a doctor's office can suggest an infection, the **Urine Culture** is the gold standard that proves it.
A UC&S test tells us two things:
- Culture: Exactly which species of bacteria is growing (e.g., E. coli, Klebsiella, or Proteus).
- Sensitivity: Which specific antibiotic will kill those bacteria. This prevents "antibiotic resistance" by ensuring we don't use the wrong medicine.
2. The Runners Up: Other Frequent Lab Guests
While urine is the most common sample, we also frequently perform the following:
- Blood Cultures: Used when a patient has a high fever or suspected "Sepsis." We grow blood in specialized bottles to see if bacteria have entered the bloodstream. This is a life-saving test.
- Gram Staining: This is the very first step in almost every microbiology test. We use purple and red dyes to categorize bacteria into "Gram-Positive" or "Gram-Negative." This gives the doctor clues within 30 minutes, even before the growth tests are done.
- Wound Swabs: Identifying bacteria in surgical wounds, ulcers, or skin infections to ensure proper healing.
- Stool Culture: Used for patients with severe diarrhea or suspected food poisoning (like Salmonella or Cholera).
3. Why Does Microbiology Take So Long?
Unlike a blood sugar test (which measures chemistry and is instant), microbiology is about **biology**. You cannot rush a living organism's growth.
- Day 1: The sample is "streaked" onto nutrient-rich agar plates (petri dishes).
- Day 2 (24 hours): The bacteria grow into visible colonies. We identify the species based on how the colonies look and smell.
- Day 3 (48 hours): We place antibiotic discs on the plates. We wait another 24 hours to see which discs stop the bacteria from growing.
4. The Danger of "Best Guess" Medicine
Many people prefer to just "buy an antibiotic" from a pharmacy without a test. This is dangerous. If you have a fungal infection and you take an antibiotic, you will not get better—and you might make the bacteria in your body more resistant. At LifeCare, we advocate for **"Evidence-Based Medicine."** We let the microbiology results lead the way, ensuring your recovery is fast and effective.
5. LifeCare's Advanced Diagnostics
Our labs at LifeCare Hospitals Kenya utilize modern technology that can identify bacteria faster than traditional methods. We use specialized automated systems for blood cultures and identification, reducing the wait time for our patients and providing our clinicians with the data they need to save lives.
Conclusion: The Science of Certainty
The "Urine Culture" might be the most common test, but every sample brought to our microbiology lab is treated with the same meticulous care. Our lab scientists are the unsung heroes of your recovery, working in the shadows to identify the enemies of your health.
Next time you are asked to wait 48 hours for a lab result, remember that we are conducting a complex biological experiment for your benefit. At LifeCare, we don't guess—we know. And that knowledge is what brings you back to health.
Frequently Asked Questions (FAQs)
Can a microbiology test detect a virus like the flu?
Standard "culture" tests are for bacteria and fungi. Viruses are much harder to grow. To detect viruses like Flu, COVID-19, or HIV, we use specialized tests like **PCR (Polymerase Chain Reaction)** which looks at the virus's DNA/RNA instead of growing it.
What does "Sensitive" mean on my lab report?
If a report says "Sensitive" (S) next to an antibiotic, it means that specific drug is highly effective at killing the bacteria in your body. If it says "Resistant" (R), the drug will not work and should not be used.
Why do I need a "Mid-Stream" urine sample?
The first bit of urine washes away bacteria sitting on the skin. The "mid-stream" represents what is actually happening inside your bladder. This prevents a "false positive" result where we find skin bacteria instead of infectious bacteria.
What is a "Negative" culture?
A negative culture means that after 48 to 72 hours of incubation, no harmful bacteria grew. This is good news! It means your symptoms may be caused by something else, like a virus or inflammation, and you probably don't need antibiotics.
